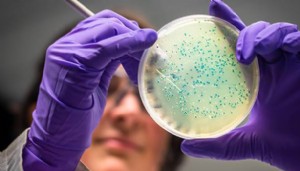

İngiltere'de koronavirüs alarmı! Vakalar patladı
İngiltere'de son 24 saatte 52 bin 9 yeni tip koronavirüs (Kovid-19) vakasının tespit edilmesiyle 17 Temmuz'dan bu yana en yüksek vaka sayısına ulaşıldı.

İngiltere Sağlık Bakanlığının açıkladığı verilere göre, ülkede virüs nedeniyle hayatını kaybedenlerin sayısı son 24 saatte 115 artarak 139 bin 146 oldu.
Aşılama programına 8 Aralık 2020'de başlayan İngiltere'de ilk dozunu yaptıranların sayısı 49 milyon 554 bin 407'ye ulaşırken, bunlardan 45 milyon 460 bin 122'sine ikinci doz da uygulandı.
İngiltere Başbakanı Boris Johnson, son günlerde salgın nedeniyle artan vaka sayıları ve ölümlere ilişkin yaptığı açıklamada, Kovid-19 vakalarının "yüksek" olduğunu belirterek, henüz yeni önlemler getirmeyeceklerini ancak her gün sayıları çok dikkatli izlediklerini söyledi.
Johnson, aşı programının önemine dikkati çekerek, vatandaşların güçlendirici Kovid-19 aşısı yaptırmaları tavsiyesinde bulundu.
İngiltere'de kış boyunca Kovid-19'la mücadele planı kapsamında hazırlanan stratejiye göre, halihazırda yürürlükte olan "A planı"na devam ediliyor.
Bu plan, yaklaşık 30 milyon kişiye güçlendirici aşı, sağlıklı 12 ila 15 yaşındakilere ise tek doz aşı sunulmasının yanı sıra kapalı mekanlarda toplanmalar için havalandırmayı, kalabalık mekanlarda el yıkamayı ve maske kullanımını teşvik ediyor.

HÜKÜMET, "B PLANI"NI YÜRÜRLÜĞE KOYMANIN HENÜZ ZAMANI GELMEDİĞİ GÖRÜŞÜNDE
Günlük Kovid-19 vakalarının 9 gündür üst üste arttığı İngiltere'de, 19 Ekim'de 223 kişinin hayatını kaybetmesiyle marttan bu yana virüse bağlı en yüksek can kaybı sayısı kaydedilmişti.
İngiltere Ulusal Sağlık Hizmetleri (NHS), vaka sayılarının artması üzerine zor bir kış döneminin önüne geçilebilmesi için hükümete bazı kısıtlamaların derhal geri getirilmesi çağrısında bulunmuştu.

Hükümet ise uyarılara rağmen kapalı ve kalabalık mekanlarda maske kullanılması zorunluluğu ve evden çalışma gibi birtakım Kovid-19 kısıtlamalarını içeren "B planı"nı halihazırda uygulamaya koymayacaklarını açıklamıştı.
İngiltere Sağlık Bakanı Sajid Javid ise dün yaptığı açıklamada, salgının hala tehdit olmaya devam ettiğini, kış aylarında günlük 100 bin Kovid-19 vakası görülebileceği uyarısında bulunmuştu.
Javid, "Bu salgın bitmedi. Hepimiz bu virüsün uzun vadede bizimle olacağını ve bir tehdit olmaya devam edeceğini hatırlamalıyız. Bu noktada B planımızı uygulamayacağız ancak teyakkuzda olacağız." ifadesini kullanmıştı.
|
Yorumcuların dikkatine… • İmlası çok bozuk, • Büyük harfle yazılan, • Habere değil yorumculara yönelik, • Diğer kişilere hakaret niteliği taşıyan, • Argo, küfür ve ırkçı ifadeler içeren, • Bir iki kelimelik, konuyu zenginleştirmeyen, yorumlar KESİNLİKLE YAYIMLANMAYACAKTIR. |
Bu haber henüz yorumlanmamış...